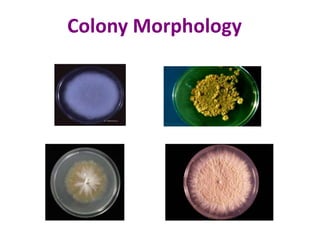
Colony Morphology

Fungi have several distinguishing morphological features:
1. They have cell walls containing chitin and lack peptidoglycan.
2. They can exist in both unicellular and multicellular forms, dividing asexually or sexually.
3. They are classified based on their structures - yeasts are unicellular, molds form branching hyphae and mycelium, and dimorphic fungi switch between yeast and mold forms based on temperature.